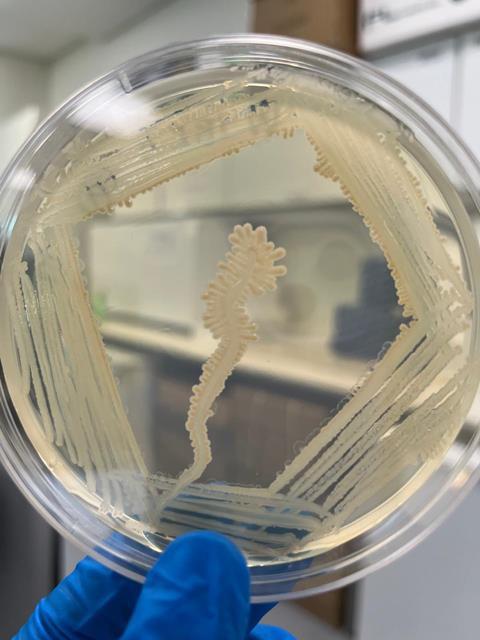
Rosado Petri Dish 1

A new paper outlines how scientists came together to put together the first microbial conservation roadmap under the leadership of Applied Microbiology International President, Professor Jack Gilbert.

The article, ‘Safeguarding Microbial Biodiversity: Microbial Conservation Specialist Group (MCSG) within the Species Survival Commission of the International Union for Conservation of Nature (IUCN)’ is published in Sustainable Microbiology, an AMI journal.
In July 2025, IUCN formally launched the MCSG within its Species Survival Commission, co-chaired by Professor Gilbert and Raquel Peixoto (KAUST / ISME). This came out of a meeting that Professor Gilbert led in May of conservation experts and microbiologists to define the premise of conservation in a microbial world.
Global coalition
“This is the first global coalition dedicated to safeguarding microbial biodiversity, which is the ‘invisible 99% of life’, to ensure that microbes are recognized as essential to the planet’s ecological, climate, and health systems,” Professor Gilbert said.
“I think this reframes conservation from saving individual species to preserving the networks of invisible life that make visible life possible—a paradigm shift toward planetary health. It also gives us a really good look into the microbial tools that can support conservation action - so that we may use microbiology to solve the world’s biggest problems.”
Microbes regulate soil fertility, carbon storage, marine productivity, and host health, yet they remain largely absent from conservation policy. Ignoring microbial biodiversity undermines climate resilience, food security, and ecosystem recovery, Professor Gilbert said, adding: “The MCSG fills this gap by embedding microbiology directly into IUCN’s conservation machinery, i.e. using Red List criteria, ecosystem assessments, and restoration programs, to make microbes visible in policy, not just in science.”
International network
Over the past two years, the founding team has built an international network of microbiologists, ecologists, legal scholars, and Indigenous knowledge holders across more than 30 countries. Together, they drafted the first microbial conservation roadmap, defining five core functions within the IUCN Species Conservation Cycle:
Assessment – develop Red List-compatible metrics for microbial communities and biobanks.
Planning – create ethical and economic frameworks for microbial interventions.
Action – pilot restoration projects using microbial solutions (coral probiotics, soil carbon microbiomes, pathogen-resistant wildlife).
Networking – connect scientists, culture collections, and Indigenous custodians worldwide.
Communication & Policy – launch campaigns such as “Invisible but Indispensable” to engage policymakers and the public.
Funding from the Gordon & Betty Moore Foundation and in kind support from AMI and ISME supports the first phase of mapping microbial hotspots, developing conservation indices, and linking existing microbial biobanks into a global archive.
Microscopic life forms
Creating a conservation framework for life forms that are microscopic posed conceptual and technical hurdles, Professor Gilbert said.
These included:
• Defining what constitutes a “microbial species” in Red List terms.
• Integrating genomic and ecological data into policy tools built for plants and animals.
• Overcoming the perception that microbes are too complex or resilient to need protection.
“Microbial conservation must contend with enormous unseen diversity and highly dynamic community structures that defy classical species concepts. Taxonomic instability, lack of long-term baselines, and the ethical handling of microbial samples (including Indigenous or human-associated microbiota) all require new definitions of ‘loss’, ‘restoration’, and ‘rights of microbes’,” Professor Gilbert said.
“But a major landmark came when the IUCN approved the MCSG as a formal Specialist Group—officially extending global conservation to microbes for the first time.”
Way forward
The group now plans to:
• Produce the first Microbial Red List framework by 2027.
• Publish global microbial hotspot maps integrating soil, marine, and host-associated ecosystems.
• Pilot conservation interventions (e.g., microbial bioremediation, coral-reef probiotics, soil carbon restoration).
• Ensure microbial indicators appear alongside plants and animals in IUCN and UN biodiversity targets by 2030
Long-term success demands sustained funding to expand microbial monitoring networks; inclusion of microbes in national biodiversity and climate policies, such as “30 by 30” and One Health frameworks; public microbial literacy—recognizing microbes as the foundation of ecosystem and human health; and integration with digital-twin and AI models to predict microbial responses to environmental change.
The paper is published in Sustainable Microbiology [LINK].
No comments yet